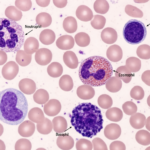
Leukocytes: 5 Essential Facts, Your Body’s Powerful Defense System

Understanding Leukocytes and Their Critical Role
Leukocytes, commonly known as white blood cells, are your body’s frontline defenders against infections, diseases, and harmful invaders. These remarkable cells patrol your bloodstream constantly, searching for threats and protecting your health every single day.
Unlike red blood cells that carry oxygen, leukocytes have a different mission entirely. They form an essential part of your immune system, identifying and destroying bacteria, viruses, parasites, and other dangerous substances that enter your body.
What Are Leukocytes Exactly?
Leukocytes are colorless blood cells produced primarily in your bone marrow. The term “leukocyte” comes from Greek words meaning “white cell,” though these cells aren’t truly white they’re actually colorless.
Your body produces billions of these cells daily. A healthy adult typically has between 4,000 to 11,000 leukocytes per microliter of blood. This number can increase dramatically when your body fights an infection or decrease due to certain medical conditions.
These incredible cells can squeeze through blood vessel walls and travel into tissues throughout your body. This ability allows them to reach infection sites quickly and start fighting pathogens immediately.

The 5 Major Types of Leukocytes
Your immune system relies on five distinct types of leukocytes, each with specialized functions:
1. Neutrophils
Neutrophils make up 50-70% of all white blood cells in your body. They’re the first responders to bacterial infections and inflammation.
These cells work by engulfing and destroying bacteria through a process called phagocytosis. When you get a cut or infection, neutrophils rush to the site within minutes.
2. Lymphocytes
Lymphocytes represent 20-40% of your white blood cells. They include three important subtypes:
B cells produce antibodies that tag harmful invaders for destruction. T cells directly attack infected cells and coordinate immune responses. Natural killer cells destroy virus-infected cells and cancer cells.
Lymphocytes provide long-term immunity, remembering past infections to respond faster if the same pathogen returns.
3. Monocytes
Monocytes comprise 2-8% of white blood cells. They’re the largest type of leukocyte and transform into macrophages when they leave the bloodstream.
Macrophages act like cellular vacuum cleaners, consuming dead cells, bacteria, and cellular debris. They also present antigens to other immune cells, helping coordinate immune responses.
4. Eosinophils
Eosinophils make up 1-4% of white blood cells. They primarily combat parasitic infections and play significant roles in allergic reactions.
These cells release toxic substances that kill parasites too large for phagocytosis. However, they can also contribute to asthma and allergic inflammation when overactive.
5. Basophils
Basophils are the rarest leukocytes, comprising less than 1% of white blood cells. Despite their small numbers, they play crucial roles in allergic reactions and inflammation.
They release histamine and other chemicals that increase blood flow to infected areas, causing the redness and swelling you experience during inflammation.
How Leukocytes Protect Your Health
Leukocytes employ multiple defense strategies to keep you healthy:
Phagocytosis: Cells like neutrophils and macrophages engulf and digest harmful microorganisms, essentially eating the invaders.
Antibody Production: B lymphocytes produce specific antibodies that neutralize pathogens and mark them for destruction.
Direct Attack: T lymphocytes and natural killer cells directly destroy infected or abnormal cells.
Chemical Warfare: Leukocytes release various chemicals that kill pathogens, attract other immune cells, and regulate inflammation.
Memory Formation: Some lymphocytes remember past infections, providing immunity against future encounters with the same pathogen.

Normal and Abnormal Leukocyte Counts
Understanding your leukocyte count helps assess your immune system health.
Normal Range: 4,000-11,000 cells per microliter of blood for adults. Children often have slightly higher counts.
Leukocytosis (High Count): When leukocyte counts exceed 11,000 cells per microliter, it indicates:
- Active infection
- Inflammation
- Stress response
- Certain medications
- Blood cancers like leukemia
Leukopenia (Low Count): When counts drop below 4,000 cells per microliter, possible causes include:
- Viral infections
- Bone marrow disorders
- Autoimmune diseases
- Chemotherapy or radiation
- Severe infections that overwhelm the immune system
Common Conditions Affecting Leukocytes
Several medical conditions directly impact leukocyte production and function:
Leukemia involves abnormal leukocyte production, where cancerous white blood cells multiply uncontrollably and crowd out healthy blood cells. According to the [National Cancer Institute] (https://www.cancer.gov/publications/dictionaries/cancer-terms/def/leukocyte), leukemia disrupts normal leukocyte function and requires specialized treatment.
HIV/AIDS progressively destroys T lymphocytes, weakening the immune system over time and making infections dangerous.
Autoimmune disorders cause leukocytes to mistakenly attack healthy tissues, leading to conditions like rheumatoid arthritis and lupus.
Infections temporarily increase leukocyte production as your body fights invaders. Bacterial infections typically cause higher increases than viral infections.
Factors That Influence Leukocyte Health
Several lifestyle factors affect your leukocyte count and function:
Nutrition: Adequate protein, vitamins C and E, zinc, and selenium support healthy leukocyte production and function.
Exercise: Moderate exercise boosts immune function, while excessive intense exercise can temporarily suppress it.
Sleep: Quality sleep is essential for optimal leukocyte production and immune system regulation.
Stress: Chronic stress elevates cortisol levels, which can suppress leukocyte function and increase infection susceptibility.
Smoking: Tobacco smoke increases white blood cell counts but impairs their effectiveness, creating a weakened immune response.
Leukocyte Testing and What Results Mean
Healthcare providers measure leukocyte counts through a Complete Blood Count (CBC) test. This simple blood test provides valuable information about your immune system status.
The test measures:
- Total white blood cell count
- Differential count (percentages of each leukocyte type)
- Cell size and shape abnormalities
Doctors order CBC tests to:
- Diagnose infections
- Monitor chronic conditions
- Evaluate immune system function
- Assess treatment effectiveness
- Screen for blood disorders
Results outside normal ranges don’t always indicate serious problems. Many factors cause temporary fluctuations, so doctors consider results alongside symptoms and medical history.
Supporting Your Leukocyte Function Naturally
You can support healthy leukocyte function through simple lifestyle choices:
Eat Immune-Boosting Foods: Include citrus fruits, berries, leafy greens, garlic, ginger, and yogurt with probiotics in your diet.
Stay Hydrated: Water helps transport leukocytes throughout your body and flushes out toxins.
Manage Stress: Practice relaxation techniques like meditation, yoga, or deep breathing exercises.
Get Adequate Sleep: Aim for 7-9 hours of quality sleep nightly to support immune cell production.
Exercise Regularly: Engage in moderate physical activity most days of the week.
Avoid Toxins: Limit alcohol consumption, quit smoking, and minimize exposure to environmental pollutants.
For more detailed information about white blood cell function, visit the [Cleveland Clinic’s comprehensive guide](https://my.clevelandclinic.org/health/body/21871-white-blood-cells).

The Future of Leukocyte Research
Scientists continue discovering new aspects of leukocyte biology that could revolutionize medicine:
Immunotherapy: Harnesses leukocytes to fight cancer by training immune cells to recognize and attack tumor cells.
CAR-T Cell Therapy: Genetically modifies T lymphocytes to target specific cancer cells, showing remarkable success in treating certain blood cancers.
Regenerative Medicine explores ways to boost leukocyte production in patients with compromised immune systems.
Personalized Medicine uses individual leukocyte profiles to customize treatment approaches for autoimmune diseases and infections.
When to Consult Healthcare Providers
Contact your doctor if you experience:
- Frequent or unusual infections
- Persistent fever without obvious cause
- Unexplained bruising or bleeding
- Extreme fatigue
- Enlarged lymph nodes
- Unexplained weight loss
These symptoms might indicate leukocyte abnormalities requiring medical evaluation.
Conclusion:
Leukocytes work tirelessly to protect your health, fighting countless battles against pathogens you never even notice. These remarkable cells represent one of nature’s most sophisticated defense systems.
Understanding how leukocytes function helps you appreciate your body’s complexity and make informed decisions about your health. By maintaining healthy lifestyle habits, you support these cellular warriors in their mission to keep you healthy.
Your leukocytes deserve recognition as the powerful, essential defenders they are. Every day, billions of these cells patrol your body, ensuring you can live, work, and thrive without constant illness.
Take care of your leukocytes, and they’ll take care of you.
Frequently Asked Questions
Why are leukocytes called white blood cells?
Leukocytes are called “white blood cells” because they appear colorless or whitish compared to red blood cells. The term “leukocyte” comes from Greek words: “leuko” meaning white and “cyte” meaning cell. However, they’re actually colorless rather than truly white.
Where are leukocytes produced?
Leukocytes are primarily produced in your bone marrow, which is the soft tissue inside your bones. Some types of leukocytes, like T lymphocytes, mature in other organs such as the thymus gland. Your body produces billions of these cells every day.
What is the main function of leukocytes?
The main function of leukocytes is to defend your body against infections and foreign invaders. They identify, attack, and destroy harmful microorganisms, remove dead cells and debris, produce antibodies, and help coordinate your immune response.
What does a high leukocyte count mean?
A high leukocyte count (leukocytosis) usually means your body is fighting an infection or dealing with inflammation. Other causes include:
- Bacterial or viral infections
- Stress or physical trauma
- Allergic reactions
- Certain medications (like steroids)
- Blood cancers like leukemia
- Pregnancy
What is leukemia and how does it affect leukocytes?
Leukemia is a cancer of blood-forming tissues that causes abnormal leukocyte production. Cancerous white blood cells multiply uncontrollably and don’t function properly, crowding out healthy blood cells. This weakens the immune system and causes various health problems.
What foods boost leukocytes?
Foods that support healthy leukocyte function include:
- Citrus fruits (oranges, lemons, grapefruits)
- Berries (blueberries, strawberries)
- Leafy greens (spinach, kale)
- Garlic and ginger
- Yogurt and fermented foods
- Nuts and seeds
- Lean proteins (chicken, fish, beans)
- Sweet potatoes and carrots
Medical Disclaimer:
This article is for educational purposes only and does not replace professional medical advice. Always follow the specific instructions provided by your healthcare provider or laboratory.